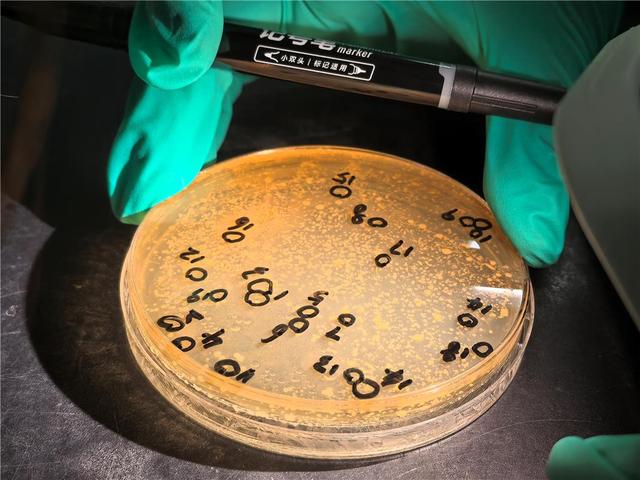

转自:草原云

在内蒙古农业大学乳品生物技术与工程教育部重点实验室,硕士研究生在离心管样品加检测试剂。
12月2日,在内蒙古农业大学乳品生物技术与工程教育部重点实验室里,恒温培养箱中的乳酸菌菌落正静静生长。这些肉眼难辨的微生物,承载着一项跨越30余年的科研长征,也从根本上推动着中国乳业核心技术的自主化进程。
博士后马腾(左二)带领团队在牧区采集乳酸菌样品。(受访者供图)11月27日,内蒙古自治区科学技术奖励大会上,由内蒙古农业大学张和平教授主持完成的“具有预防和改善代谢性疾病益生乳酸菌的筛选及开发利用”科技成果,荣获自治区科学技术进步奖一等奖。就在不久前,张和平团队的博士后马腾团队,带着“慧眼识菌——数据赋能中国菌迈向产业强国之路”项目,在第三届全国博士后创新创业大赛总决赛上斩获金奖。

在内蒙古农业大学乳品生物技术与工程教育部重点实验室,研究员进行DNA提取。
菌落平板计数。
从赛场夺冠到奖励大会上领奖,荣誉背后是一场始于1989年的漫长坚守。彼时,被誉为乳业“芯片”的乳酸菌,其生产技术被国外企业垄断,成为产业发展的关键瓶颈。
怀着“让中国酸奶用上中国菌种”的朴素信念,张和平毅然开启了全球“寻菌”之旅。他带领团队走遍46个国家,采集自然发酵乳制品等6663份样本,创新19种乳酸菌培养方法,最终分离保藏55328株乳酸菌,涵盖33个属、456个种,建成全球最大、种类最齐全的原创性乳酸菌种质资源库,为中国乳业储备了核心菌种资源。

团队成员辨别乳酸菌菌落形态。

博士后李伯海在内蒙古农业大学乳品生物技术与工程教育部重点实验室用仪器进行样品检测。
仅有资源库还不够,更要“读懂”菌种。团队从2018年开始,完成数万株菌的基因组解析,构建起全球最大的乳酸菌基因组数据库iLABdb,数据量达国际权威数据库NCBI(美国国家生物技术信息中心)的2.51倍,为每株菌制作了独一无二的“基因身份证”。

博士后张猛在全球最大乳酸菌种质资源库查看乳酸菌菌株。

明星菌株干酪乳杆菌Zhang。(电镜图)
在此基础上,团队开创性地融合人工智能与生物学,打造出益生菌智能筛选平台iProbiotics,将优质菌株的筛选时间从数月大幅缩短至2小时,准确率高达97.77%,实现了从“大海捞针”到“精准导航”的跨越。“就像为导师三十多年积累的宝藏装上了‘慧眼’。”马腾如此形容。他所带领的团队,正是在“资源库—数据库—智能平台”这一全链条创新体系的支撑下,完成了从“寻菌”“识菌”到“用菌”的关键突破。
张和平教授(左)指导菌株入库编号。(受访者供图)
亚洲最大乳酸菌生产基地——内蒙古科拓生物有限公司。
“不能让我们的科研成果一直躺在实验室里。”张和平说,要将具有益生功效的乳酸菌带给大众。目前,多个经团队深度研究的代表性菌株已成功产业化,广泛应用于益生菌食品、酸奶、奶粉等各类产品,走进了千家万户,赢得了市场认可。
创新链的坚实,正快速转化为产业价值。2023年,团队与内蒙古科拓生物有限公司达成五株菌种转让协议,单笔交易额达2000万元,创下自治区高校知识产权转化纪录。在内蒙古和林格尔新区,一座亚洲领先的乳酸菌产业化基地已然崛起,标志着科研成果正向现实生产力加速转化。

内蒙古科拓生物有限公司工作人员在生产车间检查发酵罐设备。

内蒙古科拓生物有限公司工作人员向参观者介绍益生菌产品。
从一株菌到一颗“芯”,从实验室到生产线,这条始于草原的创新之路,正是内蒙古推动科技创新和产业创新深度融合的生动实践。在这片充满生机的土地上,一代代科技工作者,正用智慧与汗水,为书写中国式现代化内蒙古新篇章提供着强劲的科技支撑。

10月28日,在第三届全国博士后创新创业大赛总决赛上,内蒙古农业大学博士后马腾团队的参赛项目“慧眼识菌——数据赋能中国菌迈向产业强国之路”获得金奖。
内蒙古日报·草原云记者:白雪 王磊
新闻编辑:陈杨
>>>查看更多:股市要闻